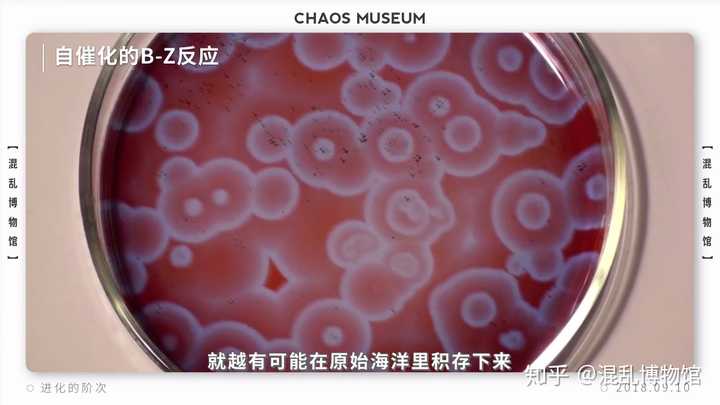
人类为什么能够在进化中胜出 混乱博物馆的回答 知乎

生命的起源 初中生物知识点

第七章微生物在自然界物质循环中的作用 Ppt Download

地球最古老物质是啥 默奇森陨石有70亿年历史 手机新浪网


太原师范学院化学系taiyuan Normal University 化学与社会第10 章营养与化学元素 Ppt Download

地球上第一个生命之谜 两大学说为你揭秘生命起源

Ppt 第五章宇宙的起源与演化powerpoint Presentation Free Download Id 5193443
人类为什么能够在进化中胜出 混乱博物馆的回答 知乎
观察下图回答问题 其中上图是生命起源化学进化过程的示意图 下图为米勒研究生命起源的化学进化过程的一个模拟实验装蚂蚁题库 Mayi173 Com

生命の誕生
转帖 生命与气候共同进化 Doc 360文库

第七章微生物在自然界物质循环中的作用 Ppt Download
Tags:
Archive
